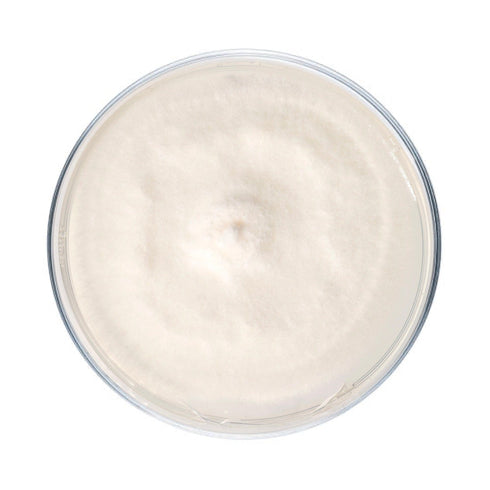
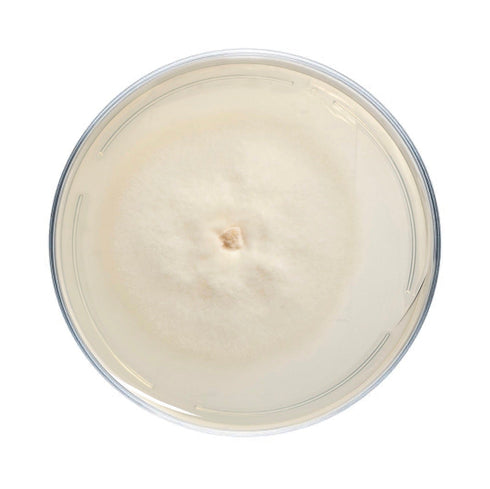
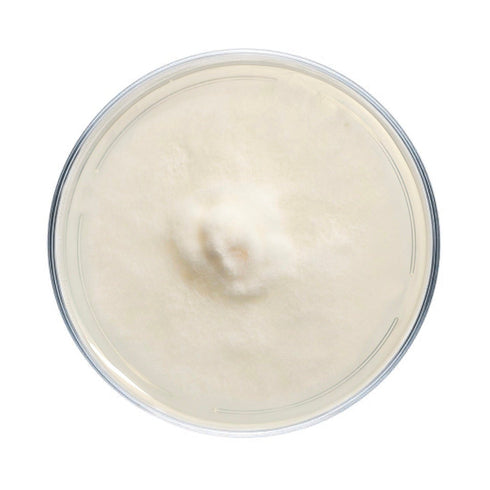

Species difficulty | Advanced |
Culture format | Agar plate |
Lab skills | Intermediate |
Shelf life | 6 months (refrigerated) |
Plate cultures are ideal for growers looking to make master bags, inoculate grain, make liquid culture, or make more plates.
Our hen of the woods (maitake) plates are made to order in our in-house lab using medical-grade petri dishes. If properly stored upon arrival, they have a shelf life of approximately 6 months. Hen of the woods (maitake) plates should be stored in the refrigerator to maintain viability. Note that mycelium cultures require basic lab skills. Handle using sterile technique to prevent contamination.
For complete descriptions of available hen of the woods (maitake) strains, click on the names below.
-
Grifola frondosa. Commercial strain from the West Coast for indoor cultivation on sawdust blocks. Hen of the Woods or "maitake" is slow and difficult to grow but prized both for its distinct taste and medicinal properties.
-
Grifola frondosa. A log strain of hen of the woods from Wisconsin. As G. frondosa is prone to being out-competed by other fungi, we recommend sterilizing sections of log and then incubating them in filter patch bags for several months after inoculation.
-
Grifola frondosa. A local wild strain of hen of the woods found growing with birch. Cultured in the fall of 2019, a particularly robust year for this species.
-
Grifola frondosa. A local wild strain of hen of the woods found growing with butternut. Cultured in 2019.
-
Grifola frondosa. A commercial hen of the woods strain from Belgium.